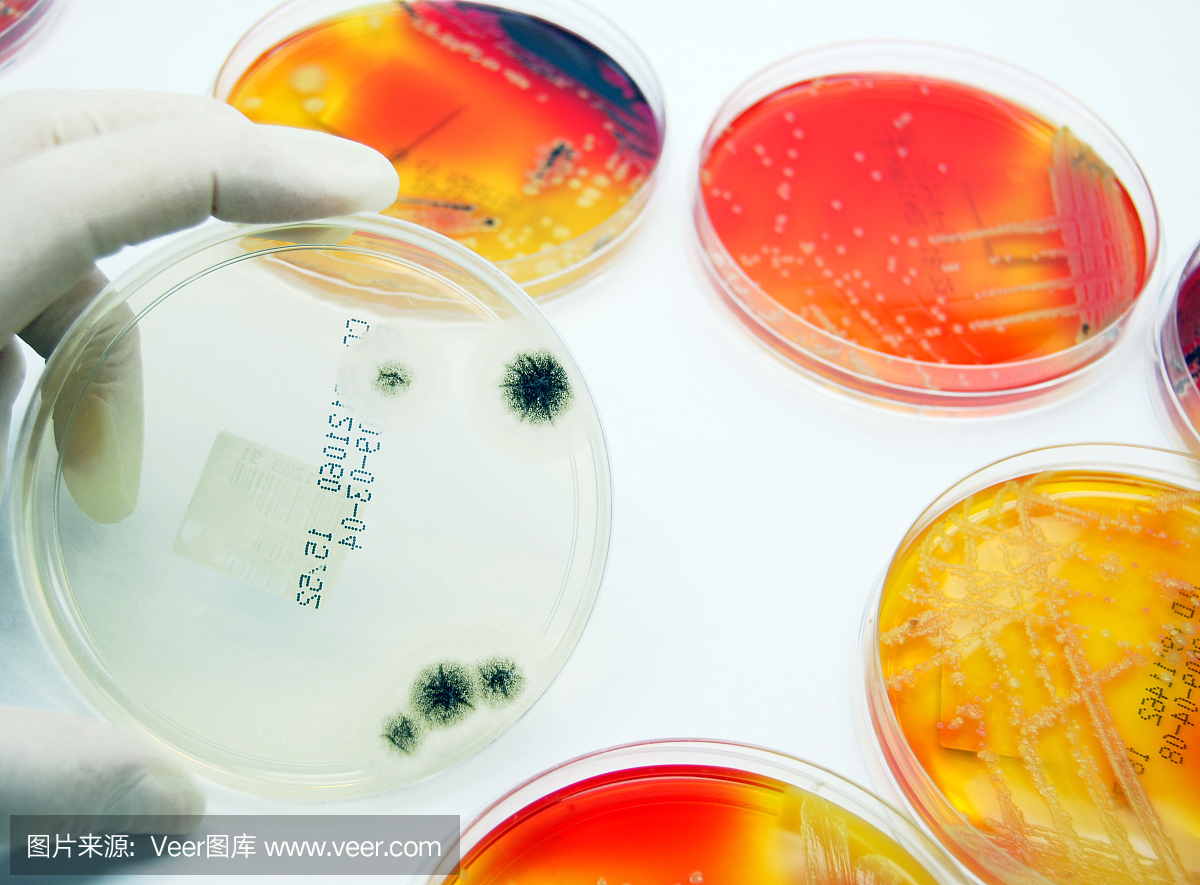
微生物学:真菌培养在前景,细菌板后面
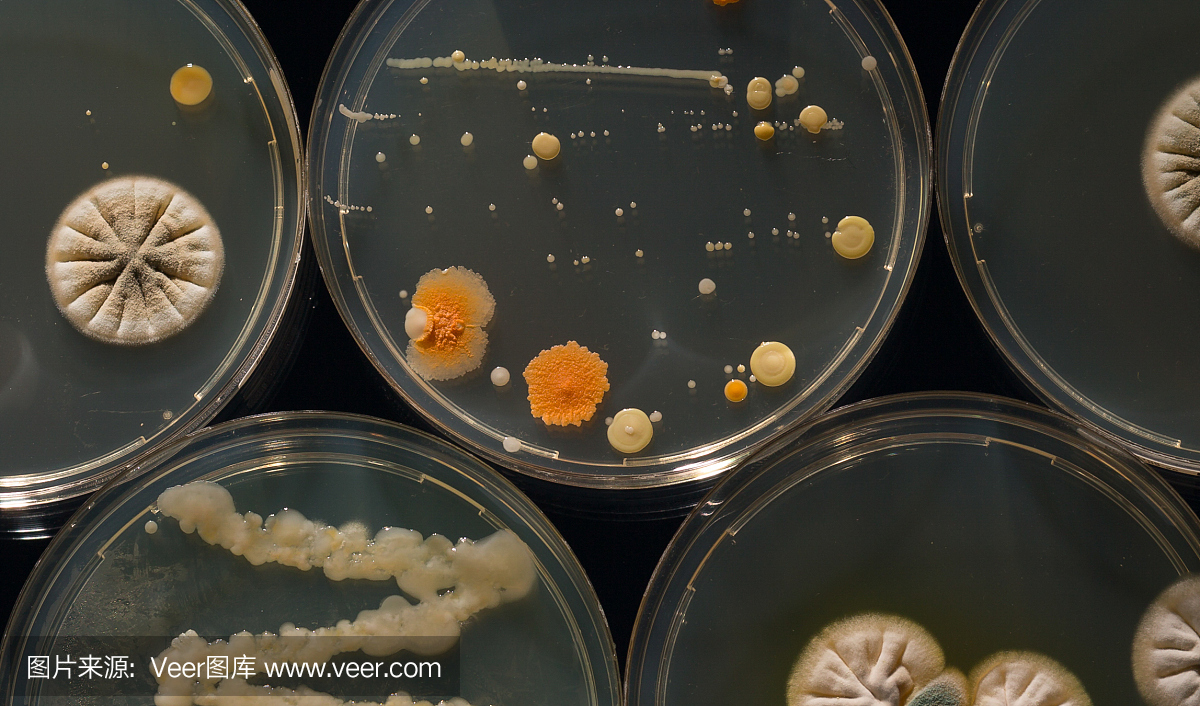
具有培养微生物,真菌和微生物培养物的培养皿

请专家帮忙鉴定真菌(真菌,土壤,平板培养,划线
640x480 - 268KB - PNG

细菌、真菌微生物培养-微生物生化培养箱价格
800x800 - 30KB - JPEG

酵母样真菌的鉴定问题,急(真菌,酵母,生理,培养
641x571 - 740KB - PNG

真菌培养中出现的晶体?附图(晶体,真菌培养,真
352x288 - 171KB - PNG

【M0142 杭微 杭州微生物 改良马丁培养基(真
533x491 - 39KB - JPEG

微生物培养基,微生物培养基,细菌培养基,生化试
320x240 - 7KB - JPEG

培养微生物,真菌和培养物的培养皿
1200x800 - 442KB - JPEG

模型发布。微生物的研究。实验室技术员检查样
1280x1272 - 277KB - JPEG
微生物学:真菌培养在前景,细菌板后面
1200x885 - 587KB - JPEG

具有培养微生物,真菌和微生物培养物的培养皿
1200x1031 - 718KB - JPEG
具有培养微生物,真菌和微生物培养物的培养皿
1200x706 - 608KB - JPEG

用于生长微生物,真菌培养物的空培养皿
1200x800 - 207KB - JPEG

模型发布。生物学课。微生物培养物生物学实验
1280x857 - 246KB - JPEG

模型发布。生物学课。学生在生物实验室准备微
1280x857 - 244KB - JPEG

培养微生物,真菌和培养物的培养皿
1200x817 - 676KB - JPEG
培养细菌真菌实验报告 文档格式:.doc 文档页数:18页 文档大小:39.0K 文档热度:文档分类:待分类 文档
B是培养细菌和真菌实验过程中的_过程,2、尝试采用细菌和真菌培养的一般方法,探究细菌和真菌的分布特点
培养细菌真菌实验报告真菌学实验报告 1.1了解真菌形态的基本特征。1.2掌握丝状真菌制片方法。1.3掌握内生
马铃薯葡萄糖琼脂培养基,简称PDA,用于培养真菌麦芽汁培养基,用于培养酵母大部分情况下,实验室都有PDA培养基
微生物实验中常用哪种培养基来培养真菌 微生物实验中常用哪种培养基来培养真菌马铃薯葡萄糖琼脂培养基,简称
实验废弃的生物活性实验材料特别是细胞和微生物(细菌、真菌和病毒等)固体培养基等要采用高压灭菌处理,
实验前不要盲目的打开培养皿.使它们保持密封状态的目的是:用无菌棉棒的目的是:防止其他微生物污染培养基.
8.在探究“检测不同环境的细菌和真菌”,实验在实验中,用无菌棉棒的目的是:防止其他微生物污染培养基.
[生物]欧阳老师你好,我做颗粒蔗糖微生物实验,使用PDA培养基,长出来一个菌落,不知简称PDA,用于培养真菌麦芽